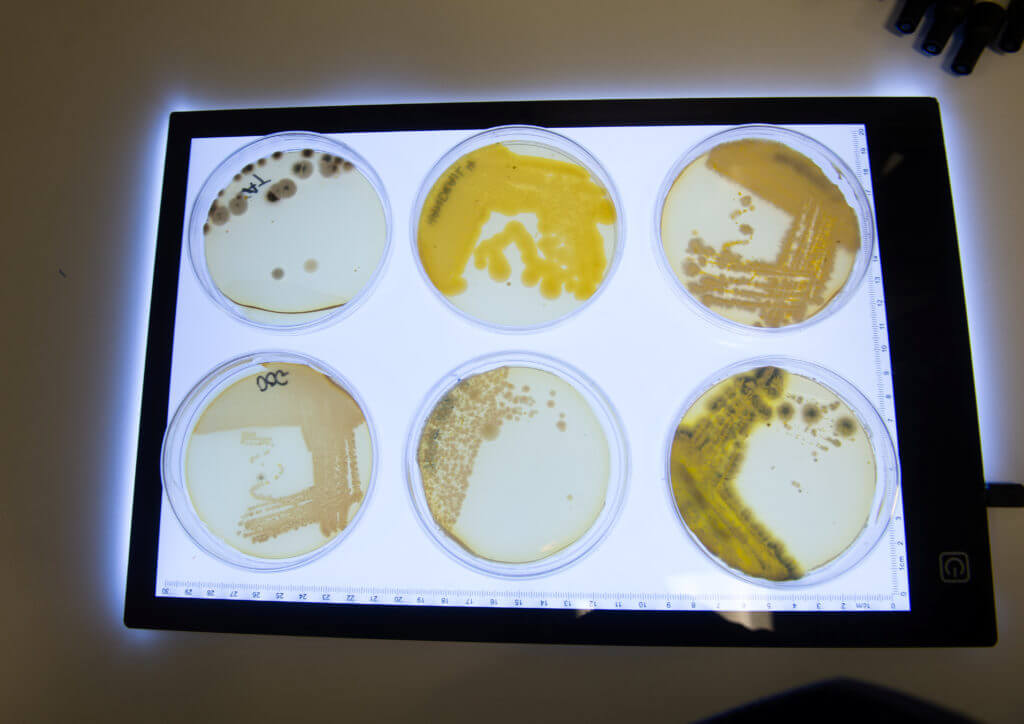
Plates swabbed from several household items.

(© M-Production - stock.adobe.com)
LONDON — Health experts are warning shoppers to wash their hands regularly after a study found both feces and vomit-inducing bugs crawling on self-service checkout screens. The investigation by British scientists, involving swabs taken from several everyday objects touched by multiple people, reveals thousands of bacteria on the ubiquitous payment machines.
E.coli, which causes vomiting, was present on nearly all the surfaces. Fecal bacteria and microbes that lead to urinary tract infections (UTIs) were found on self-service screens. A bug commonly found in the vagina, mouth, throat and gut called Candida albicans, which can cause yeast infections, was also discovered on an escalator handrail.
And shoppers may also be at risk if they share their desk with others at work, as intestinal microbes that can cause a range of infections, including UTIs, were found on computer keyboards. The findings were confirmed by scientists at the Infection Innovation Consortium (iiCON) in Liverpool, England, which led the study.
Dr. Adam Roberts, chief researcher with the agency, reports self-checkouts had a particularly high viral load. “The self-checkout samples had one of the highest bacterial loads, as we found five different types of potential disease-causing bacteria surviving on them,” he says in a statement per South West News Service. “This included Enterococcus which is found in human feces and, while this is usually harmless, it can of course lead to disease, particularly in those who may have weakened immune systems.
“We found multiple examples of E. coli and a bacteria called Klebsiella on computer keyboards,” he continues. “While both exist naturally in feces and intestines, given the right environment, they are able to cause quite severe diseases in humans, so it’s vital that we wash our hands before and after eating when working at the computer.”
Dr. Roberts warns it’s vital for shoppers to minimize the effects of this bacteria by regularly washing their hands, particularly after going to the bathroom.
“It’s vital to try to minimize their effects in terms of infection prevention and control, so when we touch our mouths or go to the toilet and don’t wash our hands, we’ve likely got bacteria from these places on our hands which can then transfer to other things – and subsequently to other people,” he adds. “If those individuals are more susceptible to infection than you are, there may be a problem.”
The study is part of a wider campaign called “Simple Things,” which was launched after researchers found two-thirds of people are worried about the spread of infectious diseases this winter. The initiative calls on people to practice four key measures to prevent the spread of winter illness: Hand-washing, sanitizing surfaces, keeping a distance when unwell, and covering sneezes or coughs.
Matt Ashton, Director of Public Health for Liverpool, urges those with vulnerable loved ones, in particular, to ensure their hands are clean before meeting them. “Our results showed that there are multiple bacteria living on objects that we touch every single day. These bacteria are completely invisible to the naked eye – surfaces may look clean but can be covered in bacteria,” he says.

“But there are simple things we can do to prevent the spread of them and stop the transfer completing its cycle,” he continues. “This is particularly important if you are visiting vulnerable relatives in hospitals and care homes, for example. Hospital admissions for illnesses like Norovirus and flu always spike at this time of year, but we can take steps to reduce how quickly germs transfer from one person to another, by simply keeping our hands clean – washing them after going to the bathroom and before and after.”
Previous research confirms the common suggestion that it’s best to wash your hands for at least 20 seconds to get rid of infectious bacteria. A mathematical model concludes that it takes that long for bacteria to escape from the “valleys” in the surface of the skin that requires a heavy stream of water and fast scrubbing. Other studies suggest only 5.3 percent of people spend 15 seconds or longer washing, rubbing and rinsing, with the average time spent being only six seconds.
South West News Service writer Douglas Whitbread contributed to this report.








How disgusting civilized humans are, eh?
London? It should be noted that certain groups of ‘immigrants’ do not use toilet paper nor have I had use for normal health/hygiene. This is true in all large urban areas of the west.
Way before this Chinese crap hit the world, mom’s advice always worked well: wash your hands after arriving home.